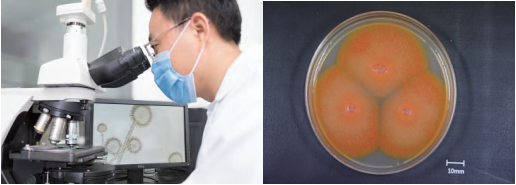

CICC微生物菌種鑒定評價技術服務始于上世紀90年代,2003年取得“國家工商總局經營許可”,2012年取得ISO 9001質量管理體系認證,2016年取得ISO 17025檢測實驗室能力認可,2018年取得CMA檢驗檢測機構資質認定,出具的檢測報告獲得國際互認。CICC提供的微生物鑒定評價技術服務為客戶開展“產品申報、質量控制、產品進出口、企業認證、污染菌溯源、發酵產品微生物解析和科研外協”等工作提供有效的技術保障。
形態學
普通細菌、酵母菌、霉菌、放線菌的菌落形態觀察,菌體形態觀察,菌體掃描電鏡觀察,透射電鏡形態學觀察。
分子生物學

特征序列分析
菌群分析
宏基因組分析
全基因組測序(二代)
全基因組完成圖測序
微生物定量分析
菌株分型(RAPD、Riboprinter、SNP分析)
功能基因序列分析
數字DDH
化學分析

MALDI-TOF MS快速鑒定系統
MIDI sherlock脂肪酸分析鑒定系統
細胞壁組分分析(氨基酸、糖)
極性脂分析
呼吸醌分析
生理生化

VITEK全自動細菌鑒定系統
API鑒定試劑條
BIOLOG自動鑒定系統
耐藥能力表型評價
動物致病性
活菌數
新種鑒定技術服務
微生物新種發表對全球系統微生物學研究影響深遠。中國已成為全球系統微生物學研究最活躍的地區,《國際系統與進化微生物學雜志》(IJSEM)建議發表新種時,提供菌株全基因組測序(WGS)信息。CICC擁有豐富的新種鑒定及論文發表服務經驗,提供包括模式菌株引進、菌種鑒定分析、公開保藏、技術咨詢等在內的新種發表“一站式”技術解決方案,檢測項目已通過ISO 17025實驗室認可,檢測結果獲得國際互認,數據可靠性具有保障,為您提供專業化、規范化、國際化的技術服務。
生物資源引進
質控微生物是一類特征明確的標準培養物及其衍生菌株產品,廣泛應用于食品、制藥、化妝品和水行業以及檢驗檢測機構的微生物學檢驗、質量控制和生產過程控制。根據實驗用途不同,質控微生物產品可分為定量產品和定性產品。定量產品包含數量一定的微生物,可應用于對接種量有要求的質控實驗;定性產品含有經準確分類鑒定的微生物,可作為陽性對照菌、標準驗證菌使用。中國工業微生物菌種保藏管理中心與多家國際知名質控微生物產品生產商分別簽訂戰略合作協議,包括法國生物梅里埃(bioMérieux)、美國賽默飛世爾科技(Thermo Fisher Scientific™)和美國Microbiologics®,成為其在中國授權的一級代理商,向國內相關行業和領域提供安全、精確和使用方便的質控微生物產品。
CICC是國際菌種保藏聯合會(WFCC)成員之一,與國際知名微生物菌種保藏機構建立了長期交流與合作關系,與國際三大質控微生物生產商簽署了中國區代理合作協議。CICC生物資源引進代理業務嚴格遵守國家相關政策法規,是我國率先開展微生物菌種引進服務的國家級菌種中心,已通過ISO 9001認證,致力于為我國工業企業、科研院所、高等院校等機構提供更安全、更專業、更便捷的菌種、細胞等生物資源引進服務。
生物制品菌種檢定專題服務
2020版《中國藥典》逐步與國際水平接軌,針對微生物菌種管理、菌種檢定、菌株分型、菌株溯源、生產過程微生物監測、環境微生物監測等內容進行修訂和補充,對我國制藥企業在微生物監控管理方面提出了新的要求和挑戰。CICC針對客戶需求,對制藥企業在新藥申報生產菌種檢測、生產過程中的微生物控制以及細胞庫長期儲存等方面開展服務。
生物制品通則

生物制品生產檢定用菌毒種管理及質量控制:針對細菌性疫苗生產用菌種、重組工程菌生產用菌種的種、屬、型分類鑒定、培養特性、菌落形態大小、革蘭氏等染色方法鏡檢、抗生素抗性、生化反應、培養物純度、全基因序列測定、目的產物表達量、透射電鏡、目的基因序列、外源基因與宿主基因的鑒定、外源基因拷貝數、整合基因穩定性、目標產物的鑒別、質粒酶切圖譜等項目進行檢測。
人用疫苗

檢測生產用菌種種子批的培養特性、純度、外源因子污染、目的基因表達穩定性、生產穩定性等。
基因治療制品

針對細菌種子批檢測菌落形態、染色鏡檢、生化特性、抗生素抗性、電鏡檢查、質粒酶切圖譜、噬菌體污染、基因型和表型的穩定、目的基因序列一致性、質粒測序、質粒拷貝數、有/無質粒細菌的比例、質粒產率等。
人用重組蛋白

應檢測主細胞庫的表型和基因型標記、目的基因拷貝數、基因插入或缺失、目的基因序列一致性、無外源因子污染、細胞基質的穩定性等。
微生態活菌制品

針對三級種子批檢測培養特性及染色鏡檢、生化反應、毒性試驗、細菌代謝產物——脂肪酸、遺傳特性、抗生素敏感性、穩定性實驗等。
細胞庫長期儲存

菌毒種經檢定后,應根據其特性,選用凍干、液氮、≤-60℃凍存或其他適當方式及時保存。
不能凍干、液氮、≤-60℃凍存的菌毒種應根據其特性,置適宜環境至少保存2份或保存于2種培養基。
益生菌類產品檢測專題

益生菌是一類當攝入一定數量水平時, 對宿主健康有益的活的微生物。近年來, 隨著公眾對健康營養需求的不斷攀升,益生菌類產品也隨之增多。菌株明確的分類學地位、安全性及產品的質量控制得到更多關注。
中國工業微生物菌種保藏管理中心專業從事微生物鑒定評價工作,通過CMA中國檢驗檢測機構能力認定和ISO 17025檢測實驗室能力認可,滿足企業對于益生菌計數、菌株精準鑒定及安全性評價的檢測需求。
飼用微生物鑒定及安全性評價專題
為保障飼用微生物菌株的質量安全,加強菌株的管理,2019年11月農業農村部發布第226號公告,對新飼料添加劑申報中微生物鑒定和菌株安全性評價提出新要求。為進一步規范新飼料和新飼料添加劑安全性評價工作,2021年11月農業農村部發布了《直接飼喂微生物和發酵制品生產菌株鑒定及其安全性評價指南》農辦牧[2021]43號文件,明確了飼料添加劑菌株的鑒定和安全性評價的技術要求。
CICC針對飼料企業客戶產品申報需求,提供符合《直接飼喂微生物和發酵制品生產菌株鑒定及其安全性評價指南》要求的“一站式”微生物技術解決方案。